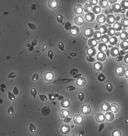

Pasteuria ramosa
| Pasteuria ramosa | |
|---|---|
![]() | |
| Daphnia magna infected with Pasteuria ramosa | |
| Scientific classification | |
| Kingdom: | Bacteria |
| Division: | Firmicutes |
| Class: | Bacilli |
| Order: | Bacillales |
| Family: | Pasteuriaceae |
| Genus: | Pasteuria |
| Species: | P. ramosa |
| Binomial name | |
| Pasteuria ramosa | |
Pasteuria ramosa is a gram-positive, endospore-forming bacterium in the Bacillus/Clostridia clade within Firmicutes. It is an obligate pathogen with cladoceran crustaceans from the Daphnia genus serving as its hosts.[1] An established and widely used coevolutionary model of host-pathogen interactions exists with P. ramosa and D. magna.[2][3]
Growth and sporulation
P. ramosa is an obligate pathogen and it can only grow inside its host. Transmission between hosts takes place through the endospore stage, and is strictly horizontal.[1] These endospores are highly resistant to different environmental stresses and can remain in the environment for decades without any deleterious effects. The infection starts when a Daphnia has ingested a spore of P. ramosa during filter feeding. The spore activates and attaches to the host esophagus. The pathogen then enters the body cavity of the host by penetrating the esophagus wall. Once inside the body cavity, the bacterium begins to propagate in cauliflower like colonies. After the infection has spread throughout the host, the bacterium begins to sporulate. The spores are shed into the environment from the dead host and can remain in the sediment for decades while maintaining their infectivity.[4]
Pathogenicity
The infection success of P. ramosa depends on its ability to attach to the host esophagus and to spread into its body cavity where the propagation of the pathogen takes place. The attachment step of the infection depends on the genotypes of the host and the bacterium, meaning that only certain host genotypes can be infected by certain strains of the bacterium.[5][4] During P. ramosa infection, the size of the Daphnia increases significantly. This phenomenon is known as pathogen-induced gigantism. The fecundity of the host is reduced due to the early induction of castration. In addition, the lifespan of the host is significantly reduced.[1]
Host range
P. ramosa has been found in D. magna, D. pulex, D. longispina,[1] D. dentifera,[6] and Moina rectirostris.[7]
Coevolutionary model with Daphnia magna
P. ramosa has coevolved with its host Daphnia magna. The mode of coevolution in this system fits the model with negative frequency dependent selection where the rare genotype is favored since the more common host genotype is more likely to become the target of a specialized pathogen.[3][8][2]
References
- 1 2 3 4 Ebert, D.; Rainey, P.; Embley, T. M.; Scholz, D. (1996). "Development, life cycle, ultrastructure and phylogenetic position of Pasteuria ramosa Metchnikoff 1888: rediscovery of an obligate endoparasite of Daphnia magna Straus". Philosophical Transactions of the Royal Society, London, Series B. 351: 1689–1701. doi:10.1098/rstb.1996.0151.
- 1 2 Carius, H. J.; Little; Ebert, D. (2001). "Genetic variation in a host-parasite association: Potential for coevolution and frequency-dependent selection". Evolution. 55: 1136–1145. doi:10.1111/j.0014-3820.2001.tb00633.x.
- 1 2 Ebert, D. (2008). "Host-parasite coevolution: Insights from the Daphnia-parasite model system". Current Opinion in Microbiology. 11: 290–301. doi:10.1016/j.mib.2008.05.012.
- 1 2 Duneau, D.; Luijckx, P.; Ben-Ami, F.; Laforsch, C.; Ebert, D. (2011). "Resolving the infection process reveals striking differences in the contribution of environment, genetics and phylogeny to host-parasite interactions". Bmc Biology. 9: 11. doi:10.1186/1741-7007-9-11.
- ↑ Luijckx, P.; Ben-Ami, F.; Mouton, L.; Du Pasquier, L.; Ebert, D. (2011). "Cloning of the unculturable parasite Pasteuria ramosa and its Daphnia host reveals extreme genotype-genotype interactions". Ecology letters. 14: 125–131. doi:10.1111/j.1461-0248.2010.01561.x.
- ↑ Auld, Stuart K. J. R.; Hall, Spencer R.; Housley Ochs, Jessica; Sebastian, Mathew; Duffy, Meghan A. (2014-08-01). "Predators and patterns of within-host growth can mediate both among-host competition and evolution of transmission potential of parasites". The American Naturalist. 184 Suppl 1: S77–90. doi:10.1086/676927. ISSN 1537-5323. PMID 25061679.
- ↑ Sayre, R. M.; Wergin, W. P.; Davis, R. E. (1977-11-01). "Occurrence in Monia rectirostris (Cladocera: Daphnidae) of a parasite morphologically similar to Pasteuria ramosa (Metchnikoff, 1888)". Canadian Journal of Microbiology. 23 (11): 1573–1579. doi:10.1139/m77-232. ISSN 0008-4166. PMID 922608.
- ↑ Decaestecker, Ellen; Vergote, Adelien; Ebert, Dieter; De Meester, Luc (2003-04-01). "Evidence for strong host clone-parasite species interactions in the Daphnia microparasite system". Evolution; International Journal of Organic Evolution. 57 (4): 784–792. doi:10.1111/j.0014-3820.2003.tb00290.x. ISSN 0014-3820. PMID 12778548.
